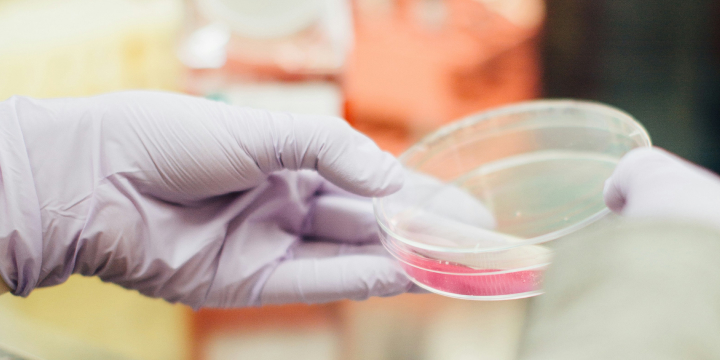

Karriere
Offene Stellenangebote:


Außendienstmitarbeiter (m/w/d) im Vertrieb für den Laborbedarf in Forschung und Industrie für die Gebiete Schleswig-Holstein und Hamburg


Außendienstmitarbeiter (m/w/d) im Vertrieb für den Laborbedarf im Krankenhaus und in externen medizinischen Laboratorien für das Gebiet Nord-Ost
Wenn Sie uns Dateianhänge schicken, beachten Sie bitte folgendes:
- nur relevante Dokumente mitversenden
- Dateigröße gering halten
- bevorzugtes Format: pdf
Kontakt
Diagonal GmbH & Co. KG
Personalabteilung
Havixbeckerstraße 62
48161 Münster